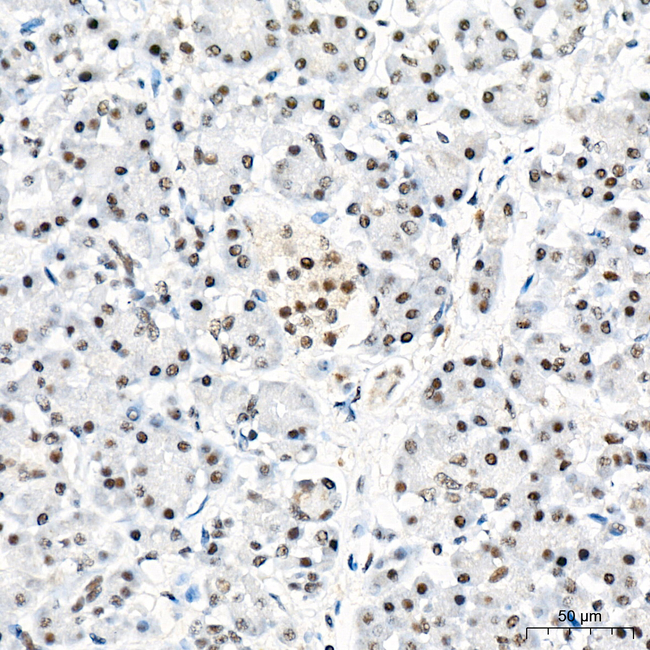
PCAF Antibody in Immunohistochemistry (Paraffin) (IHC (P))

Search
Invitrogen
PCAF Recombinant Rabbit Monoclonal Antibody (8W6M0)
{{$productOrderCtrl.translations['antibody.pdp.commerceCard.promotion.promotions']}}
{{$productOrderCtrl.translations['antibody.pdp.commerceCard.promotion.viewpromo']}}
{{$productOrderCtrl.translations['antibody.pdp.commerceCard.promotion.promocode']}}: {{promo.promoCode}} {{promo.promoTitle}} {{promo.promoDescription}}. {{$productOrderCtrl.translations['antibody.pdp.commerceCard.promotion.learnmore']}}
图: 1 / 8
PCAF Antibody (MA568918) in IHC (P)








产品信息
MA568918
种属反应
宿主/亚型
Expression System
分类
类型
克隆号
抗原
偶联物
形式
浓度
规格
纯化类型
保存液
内含物
保存条件
运输条件
靶标信息
PCAF (histone acetyltransferase KAT2B) functions as a histone acetyltransferase (HAT) to promote transcriptional activation. It has significant histone acetyltransferase activity with core histones (H3 and H4) and nucleosome core particles. PCAF also acetylates non-histone proteins such as ACLY, PLK4, and TBX5. It inhibits cell-cycle progression and counteracts the mitogenic activity of the adenoviral oncoprotein E1A. PCAF also acts as a circadian transcriptional coactivator which enhances the activity of the circadian transcriptional activators NPAS2-ARNTL/BMAL1 and CLOCK-ARNTL/BMAL1 heterodimers. It is involved in heart and limb development by mediating acetylation of TBX5 and acetylation regulating nucleocytoplasmic shutting of TBX5.
仅用于科研。不用于诊断过程。未经明确授权不得转售。
篇参考文献 (0)
生物信息学
蛋白别名: CREBBP-associated factor; Histone acetylase PCAF; Histone acetyltransferase KAT2B; Histone acetyltransferase PCAF; K(lysine) acetyltransferase 2B; Lysine acetyltransferase 2B; P/ PCAF; P/CAF; P300/CBP-associated factor; Spermidine acetyltransferase KAT2B
基因别名: A930006P13Rik; AI461839; AW536563; CAF; KAT2B; P/CAF; PCAF
UniProt ID: (Human) Q92831, (Mouse) Q9JHD1
Entrez Gene ID: (Human) 8850, (Rat) 301164, (Mouse) 18519